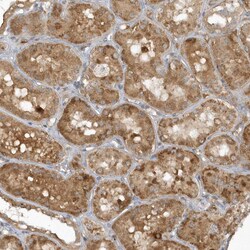

Promotional price valid on web orders only. Your contract pricing may differ. Interested in signing up for a dedicated account number?
Learn More
Learn More
Invitrogen™ THG1L Polyclonal Antibody


Rabbit Polyclonal Antibody
Supplier: Invitrogen™ PA557443
Description
Immunogen sequence: FEDQPLLYPP GFDGRVVVYP SNQTLKDYLS WRQADCHINN LYNTVFWALI QQSGLTPVQA QGRLQGTLAA D Highest antigen sequence identity to the following orthologs: Mouse - 93%, Rat - 94%.
Adds a GMP to the 5'-end of tRNA(His) after transcription and RNase P cleavage. This step is essential for proper recognition of the tRNA and for the fidelity of protein synthesis.
Specifications
| THG1L | |
| Polyclonal | |
| Unconjugated | |
| THG1L | |
| hTHG1; ICF45; IHG-1; induced by high glucose-1; interphase cyctoplasmic foci protein 45; interphase cytoplasmic foci protein 45; Probable tRNA(His) guanylyltransferase; Thg1l; tRNA-histidine guanylyltransferase; tRNA-histidine guanylyltransferase 1 like; tRNA-histidine guanylyltransferase 1-like; tRNA-histidine guanylyltransferase 1-like (S. cerevisiae); zgc:101609 | |
| Rabbit | |
| Antigen affinity chromatography | |
| RUO | |
| 54974 | |
| Store at 4°C short term. For long term storage, store at -20°C, avoiding freeze/thaw cycles. | |
| Liquid |
| Immunohistochemistry (Paraffin) | |
| 0.1 mg/mL | |
| PBS with 40% glycerol and 0.02% sodium azide; pH 7.2 | |
| Q9NWX6 | |
| THG1L | |
| Recombinant protein corresponding to Human THG1L. Recombinant protein control fragment (Product #RP-96817). | |
| 100 μL | |
| Primary | |
| Human | |
| Antibody | |
| IgG |
Product Content Correction
Your input is important to us. Please complete this form to provide feedback related to the content on this product.
Product Title
Spot an opportunity for improvement?Share a Content Correction